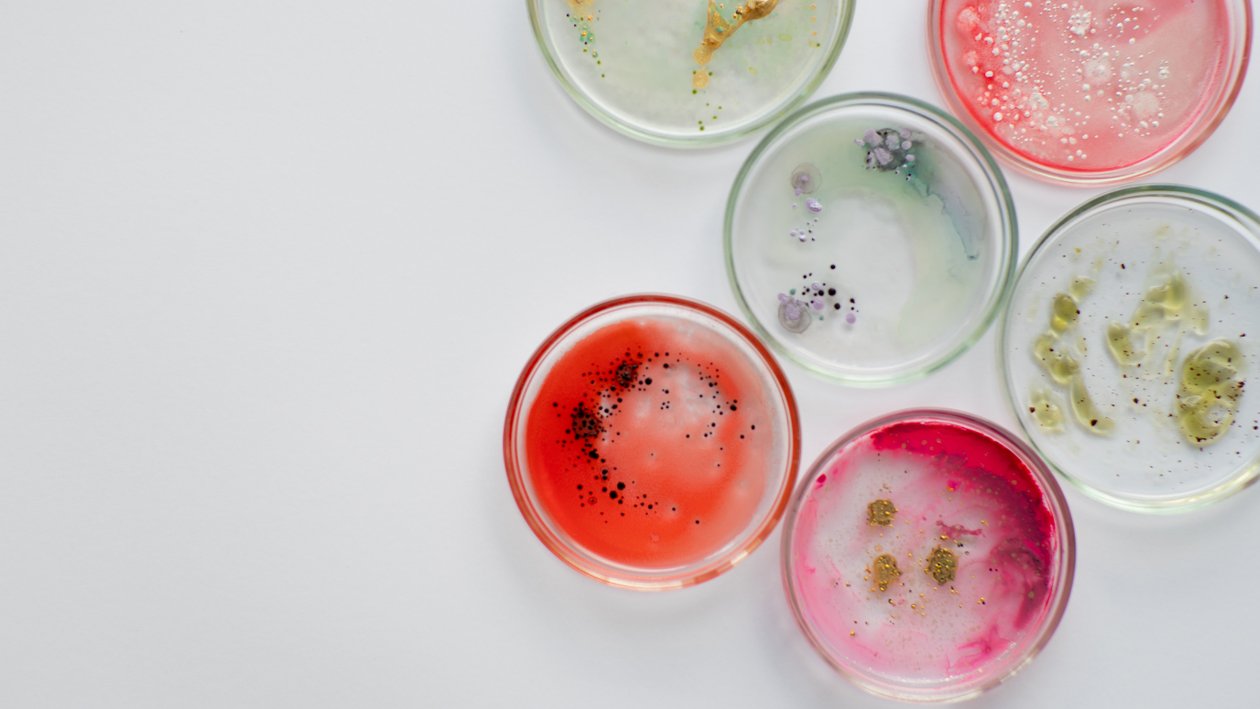

Mikrobiologie – Mikroorganismen und Wundinfektionen, Teil 2/3
13. Juni 2024 | 52 Min.
Mikrobiologie – Mikroorganismen und Wundinfektionen, Teil 2/3
Bei Start des Videos werden Informationen an Vimeo übermittelt. Mehr hierzu unter: Vimeo Datenschutzerklärung.
Suchen Sie ein bestimmtes Kapitel?
Darum geht es:
(Aufzeichung Online-Seminar) Unsere Haut, ein Wunderwerk der Natur, ist besiedelt mit Mikroorganismen. Unsere Hautflora stellt eine einzigartige Zusammenstellung von Mikroorganismen bereit, die mit uns in Koexistenz leben – sie sind Teil unseres Immunsystems.
In diesem zweiten Teil der Reihe beschäftigen wir uns mit dem Thema Wundinfektionen, bevor wir dann im dritten und letzten Teil auf mikrobiologische Untersuchungen zu sprechen kommen. Mikroorganismen können, wenn sie in Wunden gelangen, Infektionen auslösen. Daher möchten wir in diesem Seminar klären, was eine Infektion oder Entzündung ist und wie diese erkannt werden kann, aber auch welche Formen der Wundinfektionen es gibt und welche Rolle Biofilme spielen. Werden Sie zum Kenner von Mikroorganismen anhand der Farbe und des Geruchs von Wundexsudat.
Nach diesem Video…
- kennen Sie die Zusammensetzung einer Wundflora.
- verstehen Sie die Abwehrmechanismen der Haut und können Entzündungszeichen richtig erkennen und deuten.
- verstehen Sie, wie Mikroorganismen das Wundexsudat verändern und warum sie Biofilme bilden.










